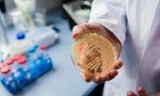
'Siêu vi khuẩn' gây chết người và kháng thuốc đang lan rộng

Battery-heated gadgets (thiết bị có pin sưởi ấm) là các thiết bị điện tử sử dụng pin sạc để tạo ra nhiệt, phục vụ các mục đích như giữ ấm cơ thể, sưởi ấm đồ vật, hoặc làm nóng các bộ phận của thiết bị, bao gồm găng tay, tất, bình nước, áo khoác, miếng dán sưởi..., được cung cấp năng lượng bởi pin lithium-ion nhỏ gọn, mang lại sự tiện lợi và di động.
Vấn đề này lại thu hút sự chú ý, sau khi du khách người Úc Ellie Tran buộc phải bỏ lại chiếc máy duỗi tóc không dây trị giá khoảng 500.000 won (399 đô la Mỹ) tại sân bay quốc tế Incheon, trước khi lên máy bay về Sydney.
Tran nói với tờ Daily Mail của Anh rằng, cô đã ký gửi cùng một loại máy này nhiều lần mà không gặp sự cố nào và thậm chí đã mang nó lên máy bay đến Hàn Quốc, nhưng khi xuống máy bay, cô lại được thông báo rằng, phải bỏ lại nó. Thiết bị này có pin lithium-ion tích hợp không thể tháo rời, điều mà các nhân viên an ninh cảnh báo là nguy cơ gây cháy.

Các hãng hàng không Hàn Quốc hiện cấm mang theo máy duỗi tóc không dây, máy uốn tóc, bàn là cầm tay và máy sưởi tay sạc điện có pin không thể tháo rời trong cả khoang hành khách và hành lý ký gửi trên tất cả các tuyến bay.
Việc siết chặt quy định không chỉ giới hạn ở các dụng cụ làm tóc. Các nhân viên an ninh tại Incheon và các trung tâm hàng không lớn khác của Hàn Quốc đang ngày càng kiểm tra kỹ lưỡng nhiều thiết bị chạy bằng pin tạo ra nhiệt hoặc ánh sáng cường độ cao.
Ngoại lệ duy nhất là các thiết bị có pin có thể tháo rời hoặc ngắt kết nối hoàn toàn bằng công tắc chế độ máy bay hoặc chế độ sẵn sàng bay, công tắc này sẽ ngắt nguồn điện đến bộ phận làm nóng.
Những quy định này phản ánh hướng dẫn về hàng hóa nguy hiểm của Tổ chức Hàng không Dân dụng Quốc tế (ICAO), trong đó khuyến khích kiểm soát chặt chẽ các thiết bị chạy bằng pin lithium đang hoạt động vì hệ thống dập lửa trong khoang hàng khó có thể khống chế được đám cháy pin.
Các nhà chức trách cho biết, việc siết chặt quy định này diễn ra sau một loạt sự cố liên quan đến cháy pin trên hoặc gần máy bay của Hàn Quốc.
Sau một loạt sự cố kể từ tháng 3/2025, hành khách ngày càng được khuyến cáo nên để pin dự phòng và thuốc lá điện tử trong túi đựng chuyên dụng và mang theo người, thay vì để trong khoang hành lý phía trên, để đảm bảo phản ứng nhanh chóng trong trường hợp hỏa hoạn. Việc sạc pin dự phòng trong suốt chuyến bay cũng bị hạn chế nghiêm ngặt.
Hướng dẫn của sân bay Incheon cũng nhấn mạnh rằng, pin lithium có công suất trên 160 watt-giờ bị cấm, và ngay cả các pin dự phòng nhỏ hơn cũng chỉ được phép mang lên cabin theo giới hạn cụ thể của hãng hàng không.
Động thái này đưa Hàn Quốc đi cùng hướng với Nhật Bản, nơi các cơ quan quản lý đã cấm các dụng cụ làm tóc không dây có pin không thể tháo rời khỏi cả khoang hành khách và khoang hành lý ký gửi. Hoa Kỳ và các nước châu Âu cũng hạn chế các vật dụng này, chỉ được phép mang trong hành lý xách tay với vỏ bảo vệ bắt buộc và khóa chống kích hoạt.